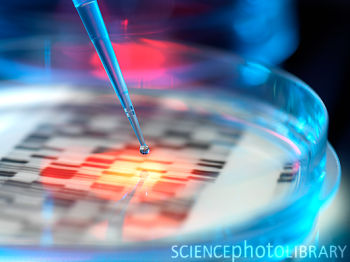

最近,英国科学家利用大肠杆菌,成功研制出生物逻辑门。这项进展使得科学家朝着打造DNA计算机的梦想又向前迈进了一步。从1994年美国科学家雷纳德•爱德曼灵感触发想到DNA计算到现在,已经过去十七年了。在这十七年里,DNA计算机从科幻小说一步一步走进我们的现实生活。几乎每隔一段时间,相关领域就会取得一些突破性进展。专家预计,一旦DNA计算机发展成熟,将会给制药业和生物医学领域带来革命性的改变。
最近,英国科学家利用大肠杆菌,成功研制出生物逻辑门。这项进展使得科学家朝着打造DNA计算机的梦想又向前迈进了一步。从1994年美国科学家雷纳德•爱德曼灵感触发想到DNA计算到现在,已经过去十七年了。在这十七年里,DNA计算机从科幻小说一步一步走进我们的现实生活。几乎每隔一段时间,相关领域就会取得一些突破性进展。专家预计,一旦DNA计算机发展成熟,将会给制药业和生物医学领域带来革命性的改变。

 DNA计算机是一种生物形式的计算机。它是利用DNA建立的一种完整的信息技术形式,以编码的DNA序列(通常意义上计算机内存)为运算对象,通过分子生物学的运算操作以解决复杂的数学难题。由于起初的DNA计算要将DNA溶于试管中实现,这种计算机由一堆装着机液体的试管组成,因此有人称之为“试管电脑”。 这种计算机“输入”的是细胞质中的RNA、蛋白质以及其他化学物质,“输出”的则是很容易辨别的分子信号。在生物医学应用上,DNA计算机能够探测和监控基因突变等细胞内一切活动的特征信息,确定癌细胞等病变细胞以及自动激发微小剂量的治疗行 。…[详细]
DNA计算机是一种生物形式的计算机。它是利用DNA建立的一种完整的信息技术形式,以编码的DNA序列(通常意义上计算机内存)为运算对象,通过分子生物学的运算操作以解决复杂的数学难题。由于起初的DNA计算要将DNA溶于试管中实现,这种计算机由一堆装着机液体的试管组成,因此有人称之为“试管电脑”。 这种计算机“输入”的是细胞质中的RNA、蛋白质以及其他化学物质,“输出”的则是很容易辨别的分子信号。在生物医学应用上,DNA计算机能够探测和监控基因突变等细胞内一切活动的特征信息,确定癌细胞等病变细胞以及自动激发微小剂量的治疗行 。…[详细]

1DNA分子是一条双螺旋的长链,上面有四种碱基,分别为:腺瞟呤(A)、鸟瞟呤(T)、胞嘧啶(C)和胸腺嘧啶(G)。DNA分子通过这些核甘酸的不同排列,能够表达出生物体各种细胞拥有的大量信息。数学家、生物学家、化学家以及计算机专家从中得到启迪。他们利用DNA能够编码信息的特点,先合成具有特定序列的DNA分子,使它们代表要求解的问题,然后通过生物酶的作用(相当于加减乘除运算),使他们相互反应,形成各种组合,最后过滤掉非正确的组合而得到的编码分子序列就是正确答案。
与传统的电子计算机相比,DNA计算机有着很多优点:(1)体积小。可同时容纳1万亿个此类计算机于一支试管中;(2)存贮量大。1立方米的DNA溶液,可以存贮1万亿亿的二进制数据,1立方厘米空间的DNA可储存的资料量超过1兆片CD容量;(3)运算快。运算速度可以达到每秒10亿次,十几个小时的DNA计算,相当于所有电脑问世以来的总运算量;(4)耗能低。仅相当于普通电脑的10亿分之一,如果放置在活体细胞内,能耗还会更低;(5)并行性。普通电脑采用的都是以顺序执行指令的方式运算,由于DNA独特的数据结构,数以亿计的DNA计算机可以同时从不同角度处理一个问题,工作一次可以进行10亿次运算,这种并行的方式工作,大大提高了效率。(6)廉价。只要是由细胞构成的有机体,都可以作为DNA的来源,因此比较廉价;(7)清洁环保。传统微处理器含有有毒材料,但DNA芯片是清洁卫生的。 此外,DNA计算机能够使科学观察与化学反应同步,节省大笔的科研经费。
与传统的电子计算机相比,DNA计算机有着很多优点:(1)体积小。可同时容纳1万亿个此类计算机于一支试管中;(2)存贮量大。1立方米的DNA溶液,可以存贮1万亿亿的二进制数据,1立方厘米空间的DNA可储存的资料量超过1兆片CD容量;(3)运算快。运算速度可以达到每秒10亿次,十几个小时的DNA计算,相当于所有电脑问世以来的总运算量;(4)耗能低。仅相当于普通电脑的10亿分之一,如果放置在活体细胞内,能耗还会更低;(5)并行性。普通电脑采用的都是以顺序执行指令的方式运算,由于DNA独特的数据结构,数以亿计的DNA计算机可以同时从不同角度处理一个问题,工作一次可以进行10亿次运算,这种并行的方式工作,大大提高了效率。(6)廉价。只要是由细胞构成的有机体,都可以作为DNA的来源,因此比较廉价;(7)清洁环保。传统微处理器含有有毒材料,但DNA芯片是清洁卫生的。 此外,DNA计算机能够使科学观察与化学反应同步,节省大笔的科研经费。

这是有史以来最先进的“生物电路”。 这种生物逻辑门是模块化的,它们可以被安装在一起,从而为未来建立更复杂的生物处理器铺平了道路。…[详细]
这种生物计算机能够进入人类细胞,通过对5种肿瘤特异性分子进行逻辑组合分析识别出特异癌细胞,从而触发癌细胞的毁灭过程。这一成果为开发出特异的抗癌治疗奠定基础。…[详细]
这种生物计算机能同时自动探测多种不同类型的分子,可用于诊断疾病、控制药物释放,实现诊断治疗一体化。…[详细]
这种细菌计算机可解决复杂数学问题,且速度远快于任何以硅 基础的计算机。…[详细]
这种DNA计算机可进行基本逻辑工作,能够应用于人工培养的肾细胞。科学家将源于其他物种的单 siRNA分子导入细胞,该DNA计算机能使编译某种荧光蛋白的目标基因关闭。…[详细]
这种DNA计算机能够更快、更准确地检测西尼罗河病毒和禽流感病毒,以及其他疾病。…[详细]
 2005年,以色列,用DNA计算机运行10亿种由DNA软件分子设计的程序
2005年,以色列,用DNA计算机运行10亿种由DNA软件分子设计的程序
这种DNA计算机采用了新的溶液处理工艺等技术,能够运行10亿种用DNA软件分子设计的程序,有潜力觉察到细胞中与多种癌症有关的异常信使RNA,为癌症诊断提供信息。…[详细]
这种DNA计算机是在以色列魏茨曼研究所的DNA计算机的基础上进行改进后完成,其中包括用双色荧光标记对输入与输出分子进行同时检测,用测序仪对自动运行过程进行实时监测,用磁珠表面反应法固化反应提高可控性操作技术等,可在一定程度上完成模拟电子计算机处理0,1信号的功能。…[详细]
这种DNA计算机主要以生化酶为计算基础来运算简单游戏。…[详细]
这是世界上第一台成型的DNA计算机,可以解决一些相对复杂的运算问题。在当时它没有什么实际用途,但它代表着DNA计算机已经迈出科幻时代,并成为现实中一种初露端倪的技术。…[详细]
科学家用一支装有特殊DNA的试管,解决了著名的 “推销员问题”:有n个城市,一个推销员要从其中某一个城市出发,唯一走遍所有城市,再回到他出发的城市,求最短的路线。这个问题在当时即使用最快的半导体来推算,也需要至少两年以上的时间,但是科学家用DNA计算只花了7天时间,令人叹为观止,从而开辟了DNA计算机研究的新纪元。…[详细]

未来的DNA计算机在研究逻辑、破译密码、基因编程、疑难病症防治以及航空航天等领域应用的独特优势, 现在电子计算机是望尘莫及,应用前景十分乐观。比如,DNA计算机的出现,使在人体内、在细胞内运行的计算机研制成为可能,它能够充当监控装置,发现潜在的致病变化,还可以在人体内合成所需的药物,治疗癌症、心脏病、动脉硬化等各种疑难病症,甚至在恢复盲人视觉方面,也将大显身手。
 一旦DNA计算技术全面成熟,真正的“人机合一”就会实现。因为大脑本身就是一台自然的DNA计算机,只要有一个接口,DNA计算机通过接口可以直接接受人脑的指挥,成为人脑的外延或扩充部分,而且它以从人体细胞吸收营养的方式来补充能量,不用外界的能量供应。像科幻小说中向大脑植入以DNA为基础的人造智能芯片,未来就像现象接种疫苗一样简单。无疑,DNA计算机的出现将给人类文明带来一个质的飞跃,给整个世界带来巨大的变化,有着无限美好的应用前景。
一旦DNA计算技术全面成熟,真正的“人机合一”就会实现。因为大脑本身就是一台自然的DNA计算机,只要有一个接口,DNA计算机通过接口可以直接接受人脑的指挥,成为人脑的外延或扩充部分,而且它以从人体细胞吸收营养的方式来补充能量,不用外界的能量供应。像科幻小说中向大脑植入以DNA为基础的人造智能芯片,未来就像现象接种疫苗一样简单。无疑,DNA计算机的出现将给人类文明带来一个质的飞跃,给整个世界带来巨大的变化,有着无限美好的应用前景。
不过,由于受目前生物技术水平的限制,DNA计算过程中,前期DNA分子链的创造和后期DNA分子链的挑选,要耗费相当的工作量。比如,阿德勒曼的“试管电脑”在几秒钟内就得出结果,但是他却花掉数周的时间去挑选正确的结果。还有,如果实验中城市数目增加到200个,那么计算所需的DNA重量将会超过地球的重量。而且数以亿计的DNA分子非常复杂,在反应过程中很容易发生变质和损伤,甚至试管壁吸附残留都可能发生致命错误。因此,DNA计算机真正进入现实生活尚需时日。
当前,世界许多国家包括我国的科学家正在积极克服和解决上述难题,预计10至20年后,DNA计算机将进入实用阶段。

 2011年9月,美国,用生物计算机摧毁癌细胞
2011年9月,美国,用生物计算机摧毁癌细胞





